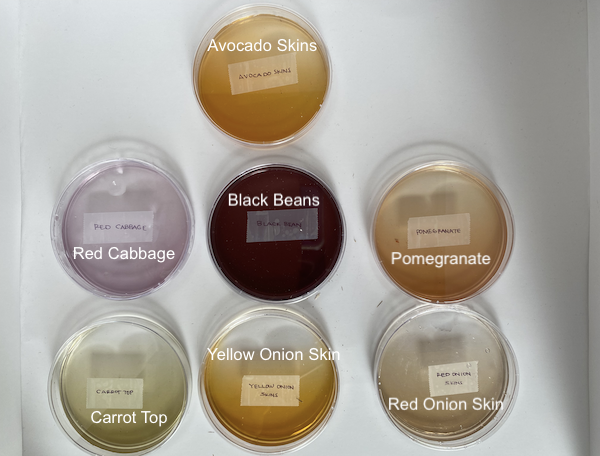
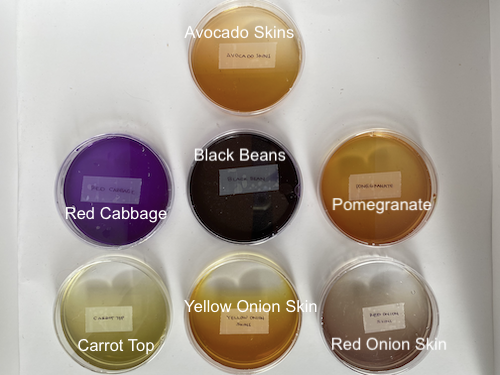

Biochromes¶
What I Made This Week¶
A Little Introduction¶
I have no experience with dyeing. Well, maybe one small experiment in the past where I tried making an agar agar based bioplastic and dyeing it with beets. It didn't go all that well but this week I got to learn more!
Biochromes are natural pigments - colored substances like melanin and carotenoids that give color to tissues in living organisms. They can be harvested from a wide variety of natural sources, including food waste, fruits, flowers, bark, roots, seeds, insects, and even bacteria. They are used to create natural dyes, inks, and pigments, often for dyeing natural fibers like cotton, wool, and silk.
This is a really good breakdown from former Fabricademy participant Emma Picanyol of how food scrap or flowers or berries transform into dyes, pigments, and inks. Thank you, Emma! This is really cool!
Inspiration¶
I recently came across an article in the Inuit Art Quarterly talking about how talented women in Talurjuaq, NU started experimenting with natural dyeing using plants from the arctic tundra about 50 years ago. This group of Inuit women, or arnait, formed a craft collective called Arnaqarvik which dedicates itself to creative development in the textile and photography realms.
I also really like the work of painter Heyshiro. He paints contemporary portraits that are, in terms of color, quite stunning and ethereal. His painting technique attributes an almost glowing quality to his subjects.
Weekly Assignment
- Include some inspiration: research on artists or projects that on natural/bacterial dyeing, local ingedients and resources
- Produce at least 1 natural dye with modifiers on fabric
- Produce 1 ink OR 1 pigment
- Document your recipes, the ingredients and process and if there have been changes, document your unexpected discoveries
- Submit some of your swatches to the analog material library of your lab (20cm x 20cm approx)
What You'll Need
- Stove
- Steel Cooking Pots (2-3)
- Spoons/Wooden spoons
- pH strips
- Petri dishes
- Paper Cups
- Coffee Filters
- Natural and/or animal fibers + fabric (Cotton, wool roving, etc.)
- Food scraps
- Digital scale
- Sodium Carbonate - For cleaning fabrics/fibers
- Aluminum Sulfate - For solidying dye color on fabrics/fibers
Dyes¶
Dyes are colored organic compounds that are soluble and used to color materials like textiles, leather, and paper by chemically bonding to the substrate.
Dyes, pigments, and inks differ and I'll delve into what pigments and inks are later.
For now, dyeing involves weighing your raw fibers/fabrics, scouring or cleaning your raw materials, mordanting, and actually dyeing.
Step 1: Weighing¶
Weighing is first. I used white cotton fabric, cotton yarn, and wool roving and weighed them on my digital scale.
Cotton Fabric = 91g Cotton Yarn = 7g Wool Roving = 100g
Total Weight of Raw Fabrics/Fibers = 198g
Step 2: Cleaning or Scouring¶
Next is scouring. Scouring is mainly done to plant fibers like cotton, etc to remove waxes and oils present in them. Now, I made a mistake and actually scoured the wool roving, which is an animal-derived fiber, but I also read it's okay, if not, recommended to scour wool before dyeing. I suppose we'll see!
You need sodium carbonate to scour. This isn't baking soda, be careful not to get this twisted. Baking soda and sodium carbonate are chemically different.
This is how you calculate how much sodium carbonate to scour.
Sodium Carbonate to Add (g): (Total Weight(g)) x 2% = 198g x 0.02 = 3.96g of Sodium Carbonate
Step 3: Mordanting¶
Mordant is a substance, alum or iron, which can be used in water alone or combined with a dye bath to enhance the fastening proces of the dye onto organic fibers. It essentially allows the dye to set into the fabric or fibers. I just used 100% Alum Dyeing Mordant or Aluminum Sulfate. Aluminum Sulfate is a type of salt that is soluble in water and is mainly used as a coagulating agent. We use alum to mordant fabrics/fibers to help brighten the colors.
Since I started preparing my fabrics/fibers at night, I decided to scour them and air dry them overnight to mordant + dye the following day.
I re-weighed my fabrics/fibers and calculated how much aluminum sulfate I needed.
New Total Weight of Materials = 205g Aluminum Sulfate to Add (g) = (New Total Weight) x 15% = 205g x 0.15 = 30.75g
I didn't pre-heat the water + aluminum sulfate. I just placed my materials in a pot of water and poured my amount of mordant in. We'll see how that results.
Step 4: Dyeing in Dye Baths¶
I prepared my dyes by dividing my food waste and letting them simmer for about 4 hours in a span of 2 days. This is kind of uncommon as this is how my schedule worked out during the weekend. Simmering food waste for a few hours and letting it sit overnight allows the dye color to become more saturated. I used avocado skins, red cabbage, red onion skins, yellow onion skins, pomegranate skins, black beans, and carrot top greens. I didn't boil the black beans. I let them sit overnight with some lukewarm water. Black beans absorb the water so be sure to have enough water at a level well above your amount of beans.
I added alum, baking soda, and citric acid to each of my dyes just to experiment and this is how they came out.
Results¶
Here are how the cotton fabric, cotton yarn, and wool roving turned out after dyeing.
Pigments¶
Pigments can be produced from leftover dye by combining it with both a metal and an alkali. In this case, I used my leftover dyes, aluminum sulfate (metal), and baking soda (alkali) to create my pigments.
How to Make Pigments¶
- Measure out about 400-500g of your desired dye bath. I chose red cabbage and black beans to develop one pigment as I am running out of time. Set it aside. _Note: For the black beans, since I only have about 250g of leftover black bean dye, I have to adjust the ratios.
- Dissolve alum in hot water, stirring continuously until it fully dissolves. A ratio of 18g of alum to 100g of hot water is typically used. Set it aside.
- Dissolve baking soda in hot water. A ratio of about 6g of baking soda to 100g of hot water is often shown to produce desired results. Set it aside.
- Slowly pour your alum solution into hot dye bath while stirring.
- Slowly pour your baking soda solution into the dye + alum solution mixture. A reaction will occur, causing foaming, so try to use a larger container. Stir the mixture as you add it.
- Allow your final mixture to sit and settle. Usually overnight.
- Pour the mixture through a coffee filter to separate the solid pigment from the liquid.
- Rinse the pigment with water and let it dry. The pigment can be left to dry at room temperature for a couple of days or dried more quickly.
- Use a mortar and pestle to grind powder more finely.
Results + Recipes¶
| Pigment | Leftover Dye Bath Used | Weight of Dye Bath | Alum in Hot Water | Baking Soda in Hot Water | Notes |
|---|---|---|---|---|---|
| Pigment 1 | Red Cabbage | 500g | 18g in 100g of Hot Water | 6g in 100g of Hot Water | - |
| Pigment 2 | Black Bean | 250g | 2.5g in 50g of Hot Water | 1.25g in 50g of Hot Water | - |
These pigments are not quite dry yet but they depict the 2nd to last step before grinding with a mortar and pestle.
Inks¶
Inks are colored liquids or viscous substances used for writing, printing, and drawing. They're composed of a colorant (like a dye or pigment), a carrier (such as water or oil), and various additives to control its properties and preservation.
So I used my leftover dyes, water as a carrier, baking soda or citric acid to play with the hues, and soy milk to thicken it. I don't have guar gum or gum arabic so I did some research and read soy milk acts as an acceptable binder. I used some turmeric oil to preserve it.
How to Make Inks¶
- Measure out 150 ml of your chosen dye bath and place in a glass container. Set it aside.
-
Measure out 50 ml of water and mix in the soy milk slowly while mixing thoroughly. It's usually recommended to use 3 parts water to 2 parts binder (soy milk, in this case).
This is how you can calculate that.
(3 parts water)/(2 parts soy milk) = (50mL of water)/x
3x = (2)(50mL of water) = 33.33mL of soy milk -
Mix the soy milk + water mixture with your 150ml of dye bath. Add a small amount of citric acid or baking soda to the mixture. Using either of the 2 will alter the ink hues.
Results + Recipes¶
I used these inks on a piece of thick, watercolor cardstock.
| Ink | Leftover Dye Bath Used | Binder | Weight of Baking Soda Added (g) | Weight of Citric Acid Added (g) | Notes |
|---|---|---|---|---|---|
| Ink 1 | Red Cabbage | Soy Milk | 3g | - | |
| Ink 2 | Red Cabbage | Soy Milk | 3g | 4g | |
| Ink 3 | Avocado Skins | Soy Milk | 4g | - | |
| Ink 4 | Yellow Onion Skins | - | - | 4g | |
| Ink 5 | Pomegranate | - | - | 8g | Strained through coffee filter 3 times for about 75mL of the dye; no 50mL of water added |
References¶
- Work of previous Fabricademy students